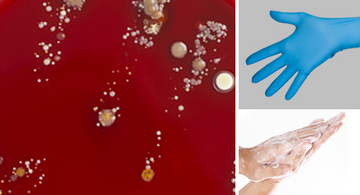
Plastic Occlusion and Staphylococcus aureus

AUGUST 2025, ISSUE 2
Bleach Baths and Eczema: What the Experts Recommend
Bee Well Therapeutics Guide to a Healthy Life
BY BEE WELL THERAPEUTICS TEAM
Bleach Baths for Eczema: What You Need to Know
A Gentle, Doctor-Approved Way to Reduce Flare-Ups
Living with eczema can be frustrating, painful, and at times exhausting. When flare-ups strike, especially during hot or humid months, finding relief becomes a top priority. One treatment that often surprises people is the bleach bath — yes, household bleach — recommended by dermatologists and supported by organizations like the National Eczema Society. It might sound harsh, but when used correctly, a dilute bleach bath can be a powerful, skin-safe way to fight bacteria that worsen eczema.
Why Use a Bleach Bath?
People with eczema have a weakened skin barrier, making them more prone to infections—especially from Staphylococcus aureus (staph bacteria). This can lead to more inflammation, itching, and delayed healing. A diluted bleach bath helps by:
• Reducing surface bacteria on the skin
• Preventing skin infections that trigger flare-ups
• Improving the effectiveness of other eczema treatments
How to Safely Take a Bleach Bath
According to the National Eczema Society, here's how to prepare one at home:
Ingredients:
- Household Bleach (plain, unscented, 4–6% sodium hypochlorite)
- Cool or lukewarm water (not hot!)
- Moisturizer and topical medication (after the bath)
Instructions:
1. Fill your bathtub with approximately 40 gallons of water (standard full tub).
2. Add ¼ cup of bleach (or 2 teaspoons per gallon if using a smaller tub).
3. Soak for 5 to 10 minutes, making sure to keep your head out of the water.
4. Rinse off with clean, warm water.
5. Gently pat dry, leaving skin slightly damp.
6. Apply any prescribed topical medications and moisturize immediately to lock in hydration.
Never pour bleach directly onto your skin and do not use concentrated industrial bleach.
Is It Safe for Children?
Yes — when used properly and under the guidance of a healthcare provider, bleach baths are considered safe for both children and adults with moderate to severe eczema. Always consult your dermatologist before beginning treatment.
Tips for Best Results:
• Limit bleach baths to 2–3 times per week, or as directed by your doctor
• Pair with gentle cleansers and barrier-protective treatments, like Bee Well Therapeutics gear, which helps lock in moisture after bathing
• Monitor for signs of irritation, and stop if the skin feels overly dry or stings
A Natural Partner to Your Routine
Bleach baths are not a cure, but they're a powerful ally in reducing bacterial load and preventing flares. Combined with gentle skincare, medical treatment, and moisture-sealing wraps like those from Bee Well Therapeutics, they can dramatically improve quality of life for eczema patients.
Final Thoughts
Bleach baths aren’t for everyone, especially those with very sensitive skin, open wounds, or allergies to chlorine. A board-certified dermatologist can help decide if this treatment is right for you or your child.